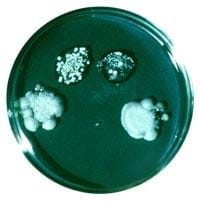
B693-4.jpg
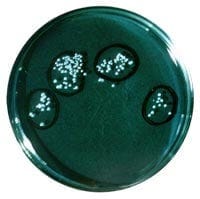
B693-6.jpg

Håndhygiene er et tema jeg har tenkt mye på. Hvor viktig er det egentlig? Er det bare noe vi er indoktrinert til å bry oss om fordi det er "tradisjon"? Eller har det virkelig noe for seg å vaske hendene etter toalettbesøket eller før man håndterer mat?
Hvor effektivt er håndvask?
Jeg fant en interessant fremstilling av effekten av håndvask. Et forsøk ble gjort hvor man brukte petriskåler fylt med agar, et gelelignende stoff som brukes for å gro bakterier i. Fire fingre ble presset lett mot skålens innhold etter ulike grader av håndvask, og så observerte man bakterieveksten.
Her her resultatet etter å ha testet med en uvasket hånd:

Kraftig bakterievekst rundt stedene hvor hver fingertupp berørte agaren altså.
Deretter ble det samme forsøket utført med en hånd som var skylt under kaldt rennende vann i 20 sekunder. Resultatet er ikke mye bedre:
Håndvask i vann uten såpe er altså svært lite effektivt fordi bakteriene i stor grad fester seg i fettet i huden, og uten såpe får man ikke løst opp og kvittet seg med disse urenhetene.
Neste forsøk ble gjort med såpe og vann med en varighet på 20 sekunder:

Dette er bedre, men gir heller ikke imponerende resultater. La oss prøve å vaske hendene med såpe og vann i 40 sekunder:
Se nå begynner det å hjelpe. Og for å ta den helt ut, så vises også et eksempel på et forsøk hvor hånden er desinfisert:

(Se flere eksempler her, bl.a. med hansker, nysing etc.)
Hva er poenget mitt? Vel, først og fremst at håndvask er viktig. Men dessverre er effekten relativt liten med mindre man vasker hendene virkelig grundig. Flere steder på web anbefales 20 sekunder som en tommelfingerregel. Tyve sekunder med skrubbing. Det er ganske lenge. En huskeregel kan være å synge "Happy birthday" inni deg selv to ganger på rad. Så lenge skal hendene vaskes. Men som vi ser av eksemplene er dette egentlig ikke spesielt effektivt. Først når man kommer opp i rundt et minutt med skrubbing, vil man ha en virkelig god effekt av håndvaskingen.
Den noe overfladiske og nesten "symbolske" håndvasken som folk utfører etter et toalettbesøk, er altså relativt virkningsløs, selv om den hvertfall får fjernet de mest "løse" bakteriene. Det viktige når man vasker hendene er friksjon. Masse friksjon. Det er friksjonen som sørger for at skitt, fett og bakterier løsner og kan skylles av hendene. En god håndvask bør altså bestå av grundig skrubbing med såpe og varmt vann i opp mot et minutt, etterfulgt av rundt 30 sekunders skylling for å fjerne såpe. For å være på den sikre siden skal man også vaske under negler og godt opp på håndleddene også, men de fleste av oss skal vel ikke inn og operere ut blindtarmen på noen, så det får være måte på...
Men hva med tørkingen?
Et annet problem jeg har tenkt mye på er at man etter å ha vasket seg tørker hendene på et håndkle som gjerne har hengt i noen dager. Vil man ikke da påføre bakterier tilbake igjen på hendene? Er ikke et fuktig tøystykke den ideelle grobunn for bakterier? Gjør man egentlig vondt verre ved å vaske seg etter et toalettbesøk?
Tja, det kommer vel an på. Det er svært viktig at håndkleet får tørke godt og at det skiftes ofte. For best hygiene anbefales tørkepapir som kastes etter bruk. Og det å tørke hendene skal ikke undervurderes. Vasker man hendene og unnlater å tørke dem skikkelig etterpå, så kan man risikere å gjøre problemet verre fordi fuktige hender lettere avgir bakterier og plukker opp nye bakterier, samt at det bidrar til økt bakterievekst på huden.
Konklusjon
Den håndvask som de fleste utfører er altså langt fra tilstrekkelig og er mer "for syns skyld" enn virkelig effektiv. Kombinasjonen av kort vask, dårlig tørking utført i et håndkle som allerede har bakterier i seg, gjør vel at vasken ikke har enorm effekt annet enn at det føles rent. En fin psykologisk boost, men ikke så veldig hensynsfullt ovenfor omgivelsene.
Her er det altså bare å skjerpe seg. Jeg har selv prøvd å ta meg sammen og vaske hendene vesentlig mye lenger enn hva jeg gjorde før, spesielt før jeg tilbereder mat til meg selv og andre. Samtidig så må man balansere dette med det noe irrasjonelle bakteriehysteriet som er ganske utpreget i vårt moderne samfunn. For min egen del prøver jeg å ikke være hysterisk ovenfor meg selv, men likevel være mer nøye enn før når det gjelder hensynet til andre mennesker som skal utsettes for "min bakterieflora".
Eneste ulempe er at jeg begynner å bli grundig lei "Happy birthday"...